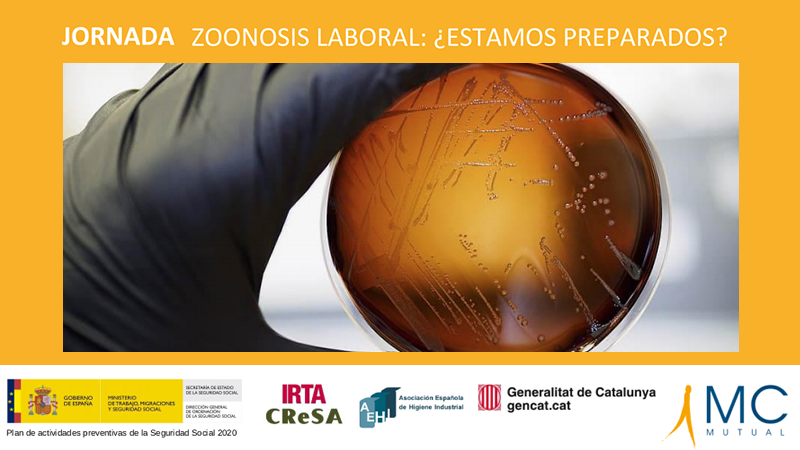
zoonosis

Las zoonosis son enfermedades que pueden transmitirse entre animales y humanos, por contacto directo o indirecto. Además de ser un problema de salud pública y de seguridad alimentaria, las zoonosis deben contemplarse también desde el punto de vista de la prevención de riesgos laborales, ya que los profesionales en contacto con animales o sus productos deben ser conscientes del riesgo al que están expuestos.
En los últimos años, los datos indican un incremento del número de casos de zoonosis, una tendencia que se preve que siga al alza. Las zoonosis, que pueden ser bacterianas, víricas o parasitarias, comprenden un gran porcentaje de las enfermedades infecciosas existentes, así como de las emergentes, y se estima que las nuevas enfermedades que surgirán en los próximos años serán de origen zoonótico.
Además de ser un problema de salud pública, las zoonosis representan también un riesgo para los profesionales que en su puesto de trabajo están en contacto con animales o sus productos, sobre el que deben tener conciencia. Asimismo, los técnicos y técnicas de prevención que evalúan estos puestos de trabajo, deben estar preparados para identificar estos riesgos y establecer las medidas preventivas necesarias.
MC Mutual organiza en Barcelona la jornada "Zoonosis laboral: ¿Estamos preparados?" en la que se quiere dar visibilidad a estos riesgos. Especialistas aportaran sus conocimientos y experiencias sobre aspectos de las zoonosis, su incidencia, la evaluación de la exposición laboral o las medidas preventivas que deben aplicarse.
Programa de ponencias
- Incidencia en España de las zoonosis en el ámbito laboral
Marta Zimmerman. Instituto Nacional de Seguridad y Salud en el Trabajo (INSST).
- Incidencia en Países Bajos de las zoonosis en el ámbito laboral
Ad de Rooij. STIGAS. Países Bajos.
- Ejemplo de Estrategia de prevención de la zoonosis
Mariano Domingo. Investigador al Centre de Recerca i Sanitat Animal (CReSA) de l’IRTA.
- Aplicación del método de evaluación específica de agentes biológicos: BIOGAVAL
Ma Eugenia López Andreu. Instituto Valenciano de Seguridad y Salud en el Trabajo (INVASSAT).
Información general
Lugar: MC MUTUAL. Salón de actos. Av. Diagonal, 394, Barcelona
Fecha: Miércoles, 19 de febrero de 2020
Horario: 9:15 a 12:30h
Plazas limitadas por orden de inscripción.
Más información e inscripciones: www.mc-mutual.com
jornadasprl@mc-mutual.com